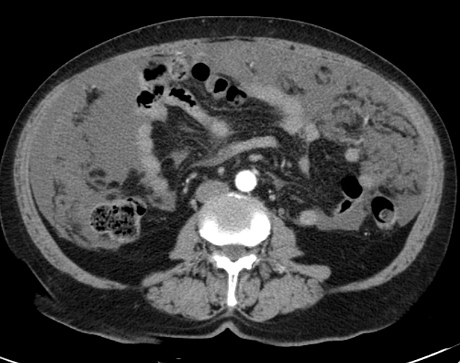
kanceromatoz bryushiny

Канцероматозом называют онкологическое поражение брюшной полости. Характеризуется вторичным появлением, с захватом серозных оболочек. Наиболее уязвимыми частями тела являются – брюшина и область плевры. Особенностью их строения считается хорошо развитая кровеносная и лимфатическая система. Вследствие чего оболочка плотно прилегает к близлежащим органам. Такое расположение приводит к усугублению ситуации при развитии ракового образования.
Причины развития канцероматоза брюшины
К основополагающим причинам появления данного злокачественного поражения относят:
- соприкосновение брюшины с близлежащими органами;
- тесное прилегание всех складок, находящихся на брюшине;
- чрезвычайно хорошо развития кровеносная и лимфатическая сеть.
Канцероматоз брюшины – опасное заболевание, справится с которым практически невозможно. Люди, страдающие злокачественным поражением, вынуждены проходить несколько этапов лечения.
Канцероматоз брюшины представляет собой серьезное осложнение, возникающее при распространении раковых клеток на поверхность брюшной полости. Врачи подчеркивают, что данное состояние часто связано с запущенными формами рака органов брюшной полости, таких как яичники, желудок или толстой кишечник. Специалисты отмечают, что ранняя диагностика и комплексный подход к лечению могут значительно улучшить прогноз для пациентов.
Медики акцентируют внимание на важности мультидисциплинарного подхода, включающего хирургов, онкологов и радиологов. Это позволяет не только эффективно контролировать симптомы, но и продлить жизнь пациентов. Врачи также рекомендуют регулярные обследования для выявления предраковых состояний, что может помочь в предотвращении развития канцероматоза. В целом, мнение врачей сводится к тому, что активное вмешательство и индивидуальный подход к каждому случаю являются ключевыми факторами в борьбе с этим тяжелым состоянием.

Чем опасно заболевание?
Опасность заболевания заключается в том, что оно быстро распространяется на близлежащие органы и системы. В результате чего побороть раковое образование практически невозможно. Это тяжелая болезнь, трудно поддающаяся лечению.
Анализы и обследования, входящие в диагностику
Канцероматоз брюшины требует проведения многих диагностических мероприятий. Заболевание отличается неспецифической клинической картиной, в силу чего его сложно диагностировать без дополнительного исследования организма. После консультации гастроэнтеролога и онколога по проявляемым симптомам, врачи могут поставить предварительный диагноз.
Дополнительно специалисты отправляют пациента на лабораторные анализы. По их результатам можно определить количество лейкоцитов, уровень СОЭ, гемоглобина. Лабораторные исследования в обязательном порядке дополняются инструментальной диагностикой. Она включает в себя УЗИ, компьютерную, магнитно-резонансную томографию. Наиболее информативной методикой считается лапароскопия. В ходе ее осуществляется изучение внутренних органов с дальнейшей биопсией.
Сложности в постановке диагноза возникают при отсутствии первичного очага поражения. Клинические проявления болезни наблюдаются в 5% всех случаев. Обусловлено это сформировавшимся поражением брюшины. Первичный очаг может характеризоваться незначительными размерами, что осложняет его выявление.
Дополнительным диагностическим мероприятием выступает определение онкомаркеров. Процедура не отличается высокой специфичностью, но при этом помогает в постановке правильного диагноза.
Канцероматоз брюшины — это серьезное заболевание, которое вызывает много обсуждений среди пациентов и медицинских специалистов. Люди, столкнувшиеся с этой проблемой, часто делятся своими переживаниями и страхами. Многие отмечают, что диагноз становится настоящим шоком, так как болезнь может развиваться незаметно. В социальных сетях можно встретить истории о борьбе с этим недугом, где пациенты делятся не только трудностями, но и моментами надежды. Некоторые говорят о важности ранней диагностики и регулярных обследований, чтобы выявить заболевание на ранних стадиях. Также обсуждаются различные методы лечения, включая химиотерапию и хирургические вмешательства. Важно отметить, что поддержка близких и общение с другими пациентами играют ключевую роль в процессе преодоления болезни. Люди стремятся найти информацию и советы, чтобы лучше понять, как справиться с этой тяжелой ситуацией.

Можно ли вылечить канцероматоз брюшины?
После постановки диагноза «канцероматоз брюшины», начинается комплексное лечение. В его основе лежит:
- хирургическое вмешательство;
- химиотерапия;
- удаление первичного очага.
Оперативное вмешательство целесообразно проводить в случае незначительного поражения. Злокачественный участок иссекается, затем вводятся антисептики и устанавливается дренаж. Следом за хирургическим вмешательством применяется химическая терапия. Она отличается своими особенностями. Препараты вводятся непосредственно в область опухоли. Злокачественные клетки под воздействием высокой температуры быстрее погибают. Эффективность методики гораздо выше по сравнению с простой химиотерапией.
Третьим этапом лечения выступает устранение первичного очага. Если не брать в учет эту тактику, злокачественное образование начнет стремительно прогрессировать. Симптоматическая терапия включает в себя устранение жидкости из брюшной полости, обезболивание, улучшение перистальтики, купирование тошноты, применение мочегонных препаратов и нормализацию состава крови.
Выживаемость, и что на нее влияет
Злокачественное поражение брюшины всегда сопровождается неблагоприятным прогнозом. При соблюдении всех лечебных мероприятий, поддерживать жизнеспособность человека можно не более одного года. Специфических процедур по профилактике не существует.
Выживаемость зависит от состояния организма человека, однако продлить жизнь более чем на 12 месяцев невозможно.

Сколько живут больные с таким диагнозом?
В большинстве случаев выявление недуга происходит на запущенной стадии. При незначительном поражении брюшины, человек может прожить несколько лет. На этот процесс влияет лечебная тактика первичного очага. При захвате большей части брюшины справится с заболеванием невозможно. Смертельный исход наступает в течение нескольких месяцев. Для поддержания жизнеспособности применяется паллиативная методика, облегчающая состояние человека.
Прогноз
Если болезнь выявлена на ранней стадии и первичный очаг поддается удалению, прогноз благоприятный. В этом случае необходимо следовать комплексной тактике воздействия на организм.
Если канцероматоз брюшины обнаружен на стадии стремительного прогрессирования, прогноз неблагоприятный. В этом случае лечение симптоматическое, его действие направлено на облегчение самочувствия больного человека.
Вопрос-ответ
Что болит при канцероматозе брюшины?
Поскольку процесс в большинстве случаев является вторичным, симптомы канцероматоза брюшины определяются состоянием первичной опухоли. При опухолях желудочно-кишечного тракта основным признаком является нарушение пищеварения, боли в животе, кишечная непроходимость; при раке печени — желтуха и т.
Можно ли остановить карциноматоз?
Однако современные технологии комплексного лечения позволяют максимально замедлить или остановить прогрессирование патологии, а в некоторых случаях добиться уменьшения очагов канцероматоза. Терапевтические и хирургические меры помогают улучшить состояние и качество жизни пациента на продолжительное время.
Советы
СОВЕТ №1
Обратитесь к врачу при первых симптомах. Если вы заметили необычные боли в животе, увеличение живота или изменения в пищеварении, не откладывайте визит к специалисту. Раннее выявление канцероматоза может значительно улучшить прогноз и увеличить шансы на успешное лечение.
СОВЕТ №2
Изучите доступные методы лечения. Канцероматоз брюшины может требовать комплексного подхода, включая химиотерапию, хирургическое вмешательство и поддерживающую терапию. Обсудите с врачом все возможные варианты и выберите наиболее подходящий для вас.
СОВЕТ №3
Поддерживайте здоровый образ жизни. Правильное питание, регулярные физические нагрузки и отказ от вредных привычек могут помочь укрепить иммунную систему и улучшить общее состояние организма, что важно в период лечения и восстановления.
СОВЕТ №4
Не стесняйтесь обращаться за поддержкой. Заболевание может быть эмоционально тяжелым, поэтому важно иметь поддержку близких или обращаться к психологу. Группы поддержки также могут стать хорошим источником информации и моральной поддержки.